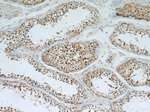
PI3K p110(beta) Antibody in Immunohistochemistry (Paraffin) (IHC (P))

Search
Proteintech
PI3K p110(beta) Polyclonal Antibody
{{$productOrderCtrl.translations['antibody.pdp.commerceCard.promotion.promotions']}}
{{$productOrderCtrl.translations['antibody.pdp.commerceCard.promotion.viewpromo']}}
{{$productOrderCtrl.translations['antibody.pdp.commerceCard.promotion.promocode']}}: {{promo.promoCode}} {{promo.promoTitle}} {{promo.promoDescription}}. {{$productOrderCtrl.translations['antibody.pdp.commerceCard.promotion.learnmore']}}
产品信息
21739-1-AP
种属反应
已发表种属
宿主/亚型
分类
类型
抗原
偶联物
形式
浓度
规格
纯化类型
保存液
内含物
保存条件
运输条件
产品详细信息
This antibody is specific to PIK3CB.
Immunogen sequence: SLKDPEVNE FRRKMRKFSE EKILSLVGLS WMDWLKQTYP PEHEPSIPEN LEDKLYGGKL IVAVHFENCQ DVFSFQVSPN MNPIKVNELA IQKRLTIHGK EDEVSPYDYV LQVSGRVEYV FGDHPLIQFQ YIRNCVMNRA LPHFILVECC KIKKMYEQEM IAIEAAINRN SSNLPLPLPP KKTRIISHVW ENNNPFQIVL VKGNKLNTEE TVKVHVRAGL FHGTELLCKT IVSSEV (139-373 aa encoded by BC114432)
靶标信息
PIK3CB (phosphatyidylinositol 4,5-biphosphate 3-kinase catalyic subunit beta isoform) is a phosphoinositide-3-kinase that phosphorylates PtdIns (phosphatidylinositol), PtdIns4P (phosphatidylinositol 4-phosphate), and PtdIns(4,5)P2 (phosphatidylinositol 4,5-biphosphate) to generate phosphatidylinositol 3,4,5-triphosphate (PIP3). PIP3 plays a key role in recruiting PH domain-containing proteins to the membrane and activating signaling cascades involved in cell growth, survival, proliferation, motility, and morphology.
仅用于科研。不用于诊断过程。未经明确授权不得转售。
生物信息学
蛋白别名: 110 kda catalytic subunit; Phosphatidylinositol 4,5-bisphosphate 3-kinase 110 kDa catalytic subunit beta; Phosphatidylinositol 4,5-bisphosphate 3-kinase catalytic subunit beta isoform; phosphoinositide-3-kinase, catalytic, beta polypeptide; PI3-kinase p110 subunit beta; PI3-kinase subunit beta; PI3K-beta; pi3kcb; PtdIns-3-kinase p110; ptdIns-3-kinase subunit beta; PtdIns-3-kinase subunit p110-beta; Serine/threonine protein kinase PIK3CB; unnamed protein product
基因别名: P110BETA; PI3K; PI3KBETA; PIK3C1; PIK3CB
UniProt ID: (Human) P42338
Entrez Gene ID: (Human) 5291